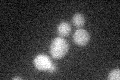
YGR216C
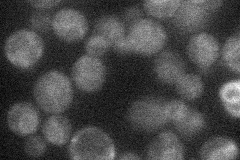
YGR216C
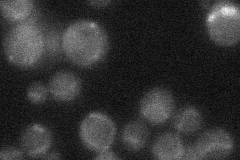
YGR216C

View description
Membrane protein involved in the synthesis of N-acetylglucosaminyl phosphatidylinositol (GlcNAc-PI), the first intermediate in the synthesis of glycosylphosphatidylinositol (GPI) anchors; human and mouse GPI1p are functional homologs
Localization:
Intensity:
Fold change:
Significance:
-
C’ GFP library in SD
below threshold18.83 -
N' NOP1pr-GFP in SD
ER21.4593 -
N' TEF2pr-mCherry in SD

below threshold6.20852 -
N' NATIVEpr-GFP in SD
below threshold20.447 -
N' TEF2pr-VC and Cyto-VN in SD

#N/A0 -
C’ GFP library in SD+DTT

cytosol14.980.79No -
C’ GFP library in SD+H2O2

cytosol17.440.92No -
C’ GFP library in Starvation Media

cytosol18.250.96No -
C’ GFP library on the background of Pup2-DaMP

below threshold -
C’ GFP library on the background of CCT mutant

below threshold16.55490.87865No
